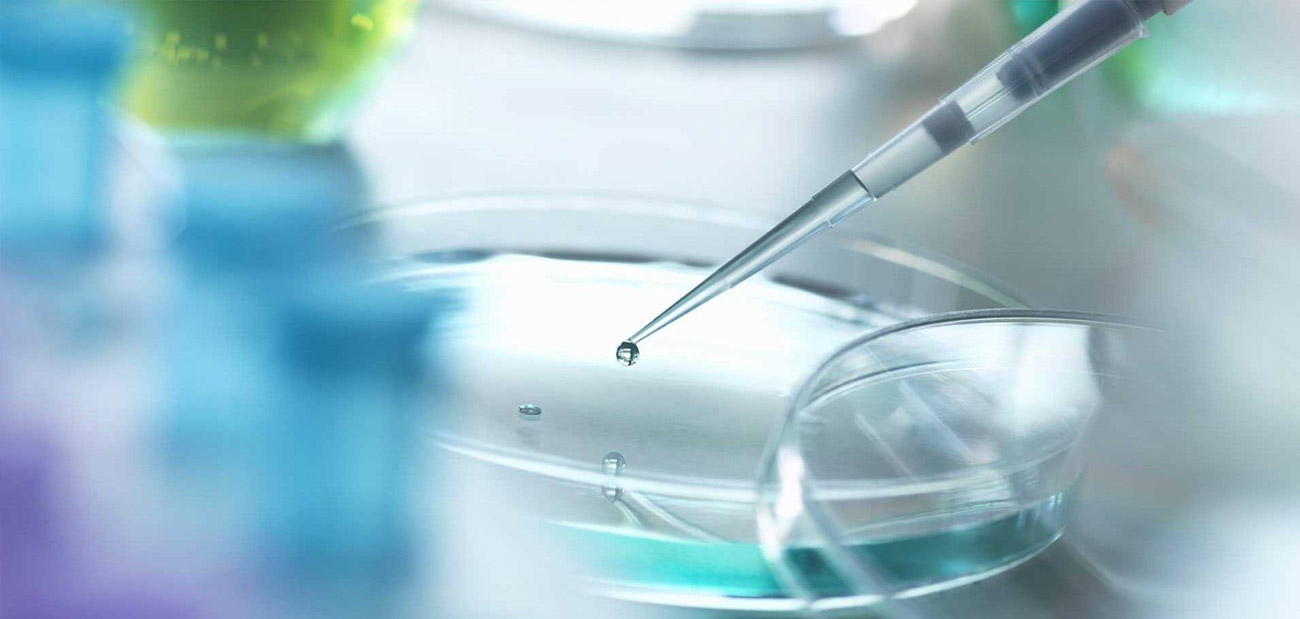

Medicina Regenerativa: Revolución en el tratamiento de enfermedades crónicas
En Vivo Cells Clínica, estamos comprometidos con ofrecer soluciones innovadoras que mejoren la salud y la calidad de vida de nuestros pacientes
Bienestar desde el primer momento: La experiencia Vivo Cells Clínica
En Vivo Cells Clínica creemos que el proceso de sanar inicia desde el momento en que cruzas la puerta. No solo nos especializamos en medicina regenerativa, también cuidamos cada detalle para que te sientas acompañado, escuchado y atendido de forma
Medicina Regenerativa: Tratamientos en Pacientes con Diabetes Tipo 2
La diabetes tipo 2 es una enfermedad crónica que afecta a millones de personas en México y el mundo. A lo largo del tiempo, sus efectos pueden deteriorar diversos órganos y sistemas del cuerpo, afectando seriamente la calidad de vida.